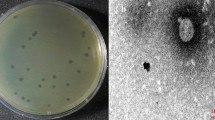

Abstract
Bacteriophages have recently been considered as an alternative biocontrol tool because of the widespread occurrence of antimicrobial-resistant Achromobacter xylosoxidans. Herein, we isolated a virulent bacteriophage (phiAxp-1) from a water sample of the Bohai sea of China that specifically infects A. xylosoxidans. Transmission electron microscopy revealed that phage phiAxp-1 belongs to the Siphoviridae. We sequenced the genome of phiAxp-1, which comprises 45,045 bp with 64 open reading frames. Most of the proteins encoded by phiAxp-1 have no similarity to sequences in the public databases. Twenty-one proteins with assigned functions share weak homology with those of other dsDNA bacteriophages infecting diverse hosts, such as Burkholderia phage KL1, Pseudomonas phage 73, Pseudomonas phage vB_Pae-Kakheti25, Pseudomonas phage vB_PaeS_SCH_Ab26, Acinetobacter phage IME_AB3 and Achromobacter phage JWX. The genome can be divided into different clusters for the head and tail structure, DNA replication and mazG. The sequence and genomic organization of bacteriophage phiAxp-1 are clearly distinct from other known Siphoviridae phages; therefore, we propose that it is a member of a novel genus of the Siphoviridae family. Furthermore, one-step growth curve and stability studies of the phage were performed, and the specific receptor of phiAxp-1 was identified as the lipopolysaccharide of A. xylosoxidans.
Similar content being viewed by others
Introduction
The worldwide rise of antibiotic-resistant bacterial strains has created the need for alternative means of controlling pathogenic bacteria1. Recently, interest in bacteriophages has increased because of their potential use as typing, diagnostic, therapeutic, decontaminating and bio-control agents2,3. In this study, Achromobacter xylosoxidans phage phiAxp-1 was isolated and characterized biologically. A. xylosoxidans is an aerobic Gram-negative bacillus that is an opportunistic human pathogen of immunocompromised hosts4. As a motile bacterium from the Achromobacter genus of the Alcaligenaceae family5, it is mainly found in moist soil and different water sources6. Recently, A. xylosoxidans was recognized as an emerging nosocomial pathogen7. This bacterium is commonly associated with a range of respiratory infections8. Although a large diversity of phages targeting a broad range of A. xylosoxidans strains have been described6, only two phages, JWAlpha and JWDelta, have been studied in detail via whole genome sequencing7. Our research aimed to isolate and characterize novel Achromobacter phages to expand the repertoire of phages available for targeting clinically significant A. xylosoxidans. Genomic analysis of bacteriophages is an important preliminary step in the development of a phage therapy protocol9. In this manuscript, we sequenced the genome of phage phiAxp-1 and characterized it further by transmission electron microscopy (TEM), and one-step growth curve and stability studies. In addition, the host component bound by the phage was identified.
Results and Discussion
Morphology
Phage phiAxp-1 was purified successfully from a lysed lawn of the host bacteria A. xylosoxidans A22732. A. xylosoxidans strain A22732 harbours a conjugative imipenem-encoding plasmid and is resistant to multiple β-lactam antibiotics, including imipenem and meropenem5. Purified phages were negatively stained and examined by TEM (Fig. 1a). The head is approximately 66 nm in diameter. The phage particles are each associated with a long non-contractile tail of approximately 230 nm in length and 15 nm in width. Collectively, these morphological features indicated that this virus belongs to the family Siphoviridae. The phage produced large, clear, round plaques of 2–3 mm in diameter on a lawn of A. xylosoxidans A22732 (Fig. 1b). Multiplication parameters of phage phiAxp-1 were determined under one-step growth curve conditions (Fig. 1c). The latent period, defined as the time interval between adsorption and the beginning of the first burst, was about 75 min. The burst time of 90 min and the average burst size of 1,742 pfu/cell were determined, calculated as the ratio of the final count of liberated phage particles to the initial count of infected bacterial cells during the latent period. Host range tests suggested that phiAxp-1 was virulent specifically to only five strains of A. xylosoxidans strains among all species tested (n = 57) (Table 1). Besides the reported multidrug-resistant strain A22732, all the other four clinical A. xylosoxidans strains were determined to be resistant to aztreonam and tobramycin.
(a) Morphology of the bacteriophage. Transmission electron micrograph (TEM) of phage phiAxp-1 at ×120000. The phages were negatively stained with 2% uranyl-acetate. The bar indicates 100 nm. (b) Plaques of phage phiAxp-1 between 2 and 3 mm in diameter on A. xylosoxidans strain A22732. (c) One-step growth curve of the bacteriophage. Phages were grown in an exponential phase culture of A. xylosoxidans strain A22732. Shown are the PFU per infected cell in cultures at different time points. Each data point is the mean from three experiments.
General features of the phiAxp-1 genome
The DNA sequence of phage phiAxp-1 is a circular double stranded DNA of 45,045 bp with a GC content of 56.02%. The genome contains 64 putative open reading frames (ORFs); however, only 21 ORFs share similarity at the protein level with other sequences deposited in GenBank. The predicted phiAxp-1 ORFs are between 30 and 1331 codons in length. Fifty-five (86%) of the phiAxp-1 genes are transcribed in one direction, designated as rightward on the genome map (Fig. 2), and nine genes are transcribed in the leftward direction. The GC content is approximately the same for both sets of ORFs. Fifty-eight of the 64 predicted ORFs start with an ATG codon, four ORFs use TTG, and two use GTG. At the ends of phiAxp-1 genes, there are 30 TAA stop codons, 30 TGA codons, three TAG codons and one AAA codon. Although we propose that phiAxp-1 is a siphovirus, the proteins of the phage have largely uncharacterized functions. Putative functional gene assignments included a large terminase subunit, capsid and tail genes, and DNA replication/modification/salvage genes. The phiAxp-1 genome has a modular organization, which is common among phages10. The proteins encoded by phiAxp-1 belong to four different functional categories: virion morphogenesis (including capsid and tail morphogenesis), DNA packaging, DNA replication, and MazG (a pyrophosphohydrolase11). Putative functional assignments and significant similarities to other sequences are listed in Table 2. The proteins with assigned functions share weak homology with proteins found in other dsDNA bacteriophages, infecting diverse hosts, such as Burkholderia phage KL1, Pseudomonas phage 73, Pseudomonas phage vB_Pae-Kakheti25, Pseudomonas phage vB_PaeS_SCH_Ab26, Acinetobacter phage IME_AB3 and Achromobacter phage JWX, with percent identities of 24–70%. Multiple genome alignments showed the weak homology of phiAxp-1 with these phages at the whole genome level (Fig. 3). In addition, 18 virion proteins were detected using liquid chromatography-electrospray ionization-tandem mass spectrometry (LC-ESI-MS/MS), of which 12 have been assigned putative functions (Table 3).
Similarity is represented by the height of the bars, which correspond to the average level of conservation in that region of the genome sequence. Completely white regions represent fragments that were not aligned or contained sequence elements specific to a particular genome. Boxes with identical colours represent local collinear blocks (LCB), indicating homologous DNA regions shared by two or more chromosomes without sequence rearrangements. LCBs indicated below the horizontal black line represent the reverse complements of the reference LCB.
Of the 21 phiAxp-1 proteins with a suggested function, half of them are structural and morphogenesis proteins. Based on BLASTP analysis, the capsid morphogenesis and DNA packaging module contains genes encoding the large terminase subunit, capsid and tail proteins (Fig. 2). As a phage with Siphoviral morphotypes, the genes for head and tail assembly are arranged together, with the head genes 5′ to the tail genes12. Terminase genes are involved in initiation of DNA synthesis and are responsible for the packaging of the concatameric DNA in phage capsids13. gp40 (terminase large subunit) shares similarity with the terminase large subunit protein from KL1 (70% identity), vB_PaeS_SCH_Ab26 (66% identity) and 73 (67% identity). Phylogenetic analysis of the available bacteriophage terminase proteins also demonstrated that phiAxp-1 could not be assigned to a branch (Fig. 4). Portal proteins are responsible for forming a ring that enables DNA to pass into the major capsid during assembly and out during infection, serving as a junction between the capsid and tail proteins13,14. gp41 encodes a protein similar to the portal proteins found in the genomes of vB_Pae-Kakheti25 (48% identity), vB_PaeS_SCH_Ab26 (48% identity) and 73 (48% identity). gp42 (head morphogenesis protein) shares weaker identity with the head morphogenesis protein from KL1 (28% identity). gp43 (scaffold protein) is similar to vB_PaeS_SCH_Ab26 orf9 (46% identity), and gp44 (major capsid protein) is similar to the major capsid protein of IME_AB3 (54% identity). The phiAxp-1 genome encodes six putative tail proteins, including a minor tail protein (gp48), a major tail tube protein (gp49), two tail chaperonin proteins (gp50–51), a tail tape measure protein (gp53) and a tail component protein (gp59) (Table 2). The tail tape measure protein (1044 amino acids [aa], encoded by gp53) is similar to the predicted KL1 tape measure protein orf21 (41% identity). The tape measure protein is important for the assembly of phage tails and is involved in tail length determination15,16. Importantly, the largest protein encoded by phiAxp-1 is the tail component protein (gp59, 1331 aa) rather than the tail tape measure protein, which is commonly the largest protein of siphovirus12. In addition, gp57–59 are similar to JWX orf25–27 (42–50% identity).
phiAxp-1 encodes a cluster of proteins involved in DNA replication. These DNA- or nucleotide binding proteins include DNA polymerase (gp62), DNA polymerase III β subunit (gp63), DNA/RNA helicase (gp2), single-stranded DNA-binding protein (gp3), recombinase (gp4), replicative primase/helicase (gp8) and exonuclease (gp28) (Fig. 2). gp62 (DNA polymerase) and gp63 (DNA polymerase III β subunit) are similar to those of IME_AB3 (55% identity) and vB_PmaS_IMEP1 (33% identity), respectively, and are thought to be responsible for genome replication. gp33 (deoxycytidylate deaminase) is similar to Thermus phage TMA orf38 (46% identity) and is involved in nucleotide salvage. A notable protein encoded by phiAxp-1 is MazG, which is a pyrophosphohydrolase that acts on ppGpp, one of the signalling molecules produced by bacteria during the stringent response9. The mazG gene provides a significant selective advantage to phages17. The putative MazG protein is encoded by phiAxp-1 gp6 and contains a MazG nucleotide pyrophosphohydrolase domain and is similar to the putative MazG protein from phage IME_AB3 (37% identity).
Stability studies
Stability studies of phage phiAxp-1 were conducted with different pHs, disinfectants, temperatures and ions, using a temperature-controlled incubator or water baths. The results are summarized in Fig. 5. The phage was most stable at pH 7, there was a significant reduction in the phage titre either above or below pH 7; the phage titre was further decreased under extremely acidic (pH 4) or basic (pH 12) conditions (Fig. 5a). No significant loss of phage titre was observed from 4 to 37 °C. However, the phage titre dramatically decreased when the temperature is over 50 °C (Fig. 5b). The activities of phage phiAxp-1 were affected in the presence of ethanol (Fig. 5c), the phage was resistant to isopropanol (Fig. 5d) at low concentrations (10%, v/v), whereas it became unstable with increasing concentrations: there was a significant reduction in phage titre at high concentration (95%, v/v). Many phages require divalent ions such as Ca2+ or Mg2+ for attachment or intracellular growth18. It may be necessary to treat phages with Ca2+ or Mg2+ to obtain an efficient phage infection. The effects of divalent ions on phage amplification were evaluated and the phage revealed divalent cation dependency for optimal infectivity. Divalent cations at no more than 20 mM were beneficial for plaque development (Fig. 5e).
Stability of phage phiAxp-1 under different pHs (a), temperatures (b), ethanol concentrations (c), isopropanol concentrations (d) and divalent ion concentrations (e). The results were expressed as a percentage of the initial viral counts. Each assay was performed as three repetitions and the values represented are the means.
Identification of the phage receptor
In Gram-negative bacteria, outer membrane proteins or lipopolysaccharide (LPS) may function as specific phage receptors19. Therefore, it was necessary to test whether the degradation of cell surface proteins or LPS could inhibit phiAxp-1 binding20. A. xylosoxidans cells were treated with either proteinase K (to destroy surface proteins) or periodate (to destroy surface carbohydrates) before the phage adsorption assay to determine the possible nature of the phage receptor20. phiAxp-1 exhibited high infection efficiency when mixed with untreated and proteinase K-treated A. xylosoxidans cells (Fig. 6a): the majority of the phages were removed from the suspension after centrifugation by binding to A. xylosoxidans cells. This suggested that the functional receptor is not a protein. The broad substrate specificity of proteinase K meant that the possibility that the receptor is a protein resistant to proteinase K is unlikely19. When the phage was incubated with periodate-treated A. xylosoxidans, the majority of the phages remained in the supernatant (Fig. 6b). The significant increase of free phage particles suggested that the phages were unable to efficiently adsorb onto the periodate-treated bacteria. Therefore, the A. xylosoxidans receptor recognized and bound by phiAxp-1 is a carbohydrate structure, most likely LPS. Significant inactivation of phages was further confirmed using LPS purified from A. xylosoxidans, which demonstrated LPS is the adsorption target (receptor) of this phage (Fig. 7). The results revealed direct correlation between A. xylosoxidans LPS concentration and phage infectivity inhibition, and 12.5 μg/ml of LPS was sufficient to inhibit the binding activity of 50% of 4.7 × 104 pfu phiAxp-1. LPS of Escherichia coli 0111:B4 was used as a negative control. As shown in Fig. 7, E. coli LPS showed no phage inactivating ability compared with that from A. xylosoxidans LPS, thus indicating that LPS from A. xylosoxidans is specific for phage phiAxp-1. In this respect, it is consistent with the features of most phages with Gram-negative bacterial hosts.
The results are shown as residual PFU percentages. (A) Effect of proteinase K treatment on the adsorption of phiAxp-1 to A. xylosoxidans strain A22732. (B) Effect of periodate treatment on the adsorption of phiAxp-1 to A. xylosoxidans strain A22732. The control (LB and “A22732 + acetate”), untreated strain (A22732), and treatment (“A22732 + ProtK” for proteinase K treatment and “A22732 + IO4−” for periodate treatment) groups were tested for adsorption, as indicated in the x-axes. Error bars denote statistical variations. Significance was determined by a Student’s t test for comparison between the treated and the untreated groups. *P 0.05.
Concluding Remarks
The clinical relevance of nosocomially-acquired infections caused by multi-resistant Achromobacter strains is increasing rapidly, becoming a critical problem7. Phages are re-emerging as promising potential therapies for the treatment of bacterial infections21. Here, we report a preliminary analysis of A. xylosoxidans bacteriophage phiAxp-1. This article presents the sequence analysis and a detailed genome annotation of phage phiAxp-1. The genomic data constitute an important resource to study and engineer phages to control specific bacterial species22. The analysis showed that phiAxp-1 does not easily fit into previously established groups of dsDNA bacterial viruses and may represent a distinct branch of the Siphoviridae family.
Stability is the primary requirement for any possible commercial use of the phage, which can reduce the cost of storage significantly23. Therefore, in this study, the stability tests on phage phiAxp-1 under different pHs, temperatures, disinfectants and ions were performed for the potential practical application of phiAxp-1. Despite its importance, the molecular interactions between phiAxp-1 and the surface of A. xylosoxidans are still poorly understood. Phages bind to unique host-specific structures, allowing them to recognize a suitable host in a mixed bacterial population24. In this study, periodate treatment of A. xylosoxidans, but not proteinase K treatment, inhibited phage binding. Furthermore, purified LPS from the A. xylosoxidans showed phage-inactivating capacities thus confirmed that LPS of A. xylosoxidans is the receptor of phage phiAxp-1.
The emergence of phage-resistant mutants affecting phage receptors is a major concern regarding the use of phage therapy25. The LPS of Gram-negative bacteria commonly represents an important virulence factor and is of great significance in the pathophysiology of many disease processes26. Thus, the phage-resistant mutants resulting from the loss or alteration of the receptor will be avirulent or attenuated. Such mutants do not pose a problem during bacteriophage treatment25. Our future work will explore this possibility. These results suggest that phage phiAxp-1 is a promising candidate for controlling A. xylosoxidans and represents an advance in our current knowledge of A. xylosoxidans phages.
Methods
Bacterial strains and growth media
Luria-Bertani (LB) broth medium was used to grow the bacterial strains and to propagate the phage. A. xylosoxidans strain A22732 was used as the indicator strain for phage isolation.
Isolation of phage and host range determination
phiAxp-1 was isolated from a water sample of the Bohai sea of China using a double agar overlay plaque assay, as described previously for the isolation of lytic phages27. The water sample was centrifuged at 8,000 × g for 10 min to remove the solid impurities. The supernatants were filtered through a 0.22-μm pore-size membrane filter to remove bacterial debris. The filtrates were then mixed with A. xylosoxidans culture to enrich the phage at 37 °C. The culture was centrifuged, and the supernatant was filtered through a 0.22-μm pore-size membrane to remove the residual bacterial cells. Aliquots of the diluted filtrate were mixed with A. xylosoxidans culture. Then, 3 mL of molten top soft nutrient agar (0.7% agar) were overlaid on the solidified base nutrient agar (1.5% agar)28. Following incubation for 10 h at 37 °C, clear phage plaques were picked from the plate. The phage titre was determined using the double-layered method. The host range of the phage was tested against 57 clinical strains from our microorganism centre, as determined by standard spot tests29. Briefly, 10 μl from a purified phage suspension containing approximately 108 pfu/mL were spotted in the middle of a lawn of bacteria and left to dry before incubation overnight. Bacterial sensitivity to a bacteriophage was established by bacterial lysis at the spot where the phage was deposited. Each strain was tested three times at 37 °C.
TEM
To prepare phiAxp-1 for transmission electron microscopy studies, cell debris from 500 mL of A. xylosoxidans strain A22732 infected with phiAxp-1 was pelleted by centrifugation. Phage particles were precipitated with 1 M NaCl and 10% polyethylene glycol (PEG) 8000 at 4 °C with stirring for 60 min. The precipitated phage particles were harvested. Phage particles were resuspended in Saline - magnesium (SM) diluent plus gelatin (SMG) (50 mM Tris-HCl [pH 7.5] containing 100 mM NaCl, 8.1 mM MgSO4 and 0.01% (w/v) gelatin) and extracted with an equal volume of chloroform. After low-speed centrifugation, the aqueous phase was sedimented at about 25,000 × g for 60 min. Phage particles were negatively stained with 2% (wt/vol) phosphotungstic acid (pH 7), air dried, and examined under a Philips EM 300 electron microscope operated at 80 kV and 120 KEv.
One-step growth curve
One-step growth experiments were performed as described previously30. Host strain A. xylosoxidans strain A22732 cells were harvested at exponential growth and resuspended in LB. The phage phiAxp-1 was added at a multiplicity of infection (MOI) of 0.0005 and allowed to adsorb for 5 min at room temperature. The mixture was centrifuged and the pellets containing infected cells were suspended in 10 ml of LB, followed by incubation at 37 °C. Samples were taken at 10 min intervals (up to 110 min) and immediately diluted, and then titres were determined by the double-layered-agar plate method.
Stability studies
A temperature-controlled incubator or water bath was used to determine the stabilities at different pH, disinfectants, ions or temperatures. After the desired treatment, the tube was cooled down slowly, placed in an ice water bath and samples were assayed to determine surviving pfu. Briefly, for thermal stability tests, aliquots of phage suspensions were incubated at 37 °C (pH 1–14) for 60 min, and then the phage titres were tested by the double-layer agar method. For pH stability tests, aliquots of phage suspensions were incubated at 4, 25, 37, 50, 60, 70 and 80 °C for 75 min; the phage titres were determined every 15 min. For disinfectant sensitivity, aliquots of phage suspensions were incubated with different concentrations of ethanol or isopropanol for 90 min; the phage titres were determined every 30 min. For divalent ion sensitivity, aliquots of phage suspensions were assayed on solidified base nutrient agar (1.5% agar) with different concentrations of Mg2+ or Ca2+ and the phage titres were tested.
Isolation of phage DNA, genome sequencing and assembly
phiAxp-1 DNA was extracted from purified phage particles with phenol-chloroform (24:1, vol/vol) and precipitated with 100% ethanol. The samples were visualized on 0.7–1.0% agarose gels, and the purified phage DNA was sequenced using an Illumina HiSeq2500 sequencer. The sequence reads were filtered to remove low quality sequences, trimmed to remove adaptor sequences and the filtered sequences were assembled. The final assembled sequence was searched against the current protein and nucleotide databases ( http://www.ncbi.nlm.nih.gov/) using Basic Local Alignment Search Tool (BLAST) software31. BLASTP was used to determine the similarity to described proteins in the National Center for Biotechnology Information [NCBI] database ( http://www.ncbi.nlm.nih.gov). The CLC Main Workbench, version 6.1.1 (CLC bio, Aarhus, Denmark) was used for genome annotation. Computer-based predictions were checked manually. Phylogenetic analysis with the published genome sequences of related phages was conducted using ClustalW (Slow/Accurate, IUB). Whole genome comparisons were carried out using Mauve32. LC/ESI/MS/MS spectra (Q-TOF Ultima API, Micromass UK Ltd.) were used to identify the phage proteins, as described previously33.
Identification of the phage receptor
Receptor properties of phiAxp-1 were determined as described previously19. Briefly, A. xylosoxidans A22732 cultures were treated with sodium acetate (50 mM, pH 5.2) containing 100 mM IO4− at room temperature for 2 h (protected from light) or proteinase K (0.2 mg/ml; Promega) at 37 °C for 3 h to determine whether proteinase K or periodate can destroy the phage receptor. The phage adsorption assay was then performed as previously described20. LB was used as a non-adsorbing control in each assay, and the phage titre in the control supernatant was set to 100%. Each assay was performed in duplicate and repeated twice19.
Phage inactivation by LPS
LPS extraction from A. xylosoxidans was performed using an LPS extraction kit from Intron Biotechnology (17144; Boca Scientific, Boca Raton, FL, USA), according to the manufacturer’s instructions. LPS from Escherichia coli O111:B4 purchased from Sigma-Aldrich, Inc. (L2630; Sigma, USA) was used as a negative control to ensure that the possible effect was specific to A. xylosoxidans LPS. Both LPS of Escherichia coli O111:B4 and A. xylosoxidans A22732 are smooth type. The phage inactivation by LPS was performed as previously described34.
Nucleotide sequence accession number
The annotated genome sequence for the phage phiAxp-1 was deposited in the NCBI nucleotide database under the accession number KP313532.
Additional Information
How to cite this article: Li, E. et al. Characterization of a novel Achromobacter xylosoxidans specific siphoviruse: phiAxp-1. Sci. Rep. 6, 21943; doi: 10.1038/srep21943 (2016).
References
Amarillas, L. et al. Genomic Analysis of Broad-Host-Range Enterobacteriophage Av-05. Genome Announc 3, doi: 10.1128/genomeA.00282-15 (2015).
Hagens, S. & Loessner, M. J. Bacteriophage for biocontrol of foodborne pathogens: calculations and considerations. Curr Pharm Biotechnol 11, 58–68 (2010).
Leon-Velarde, C. G. et al. Complete genome sequence of bacteriophage vB_YenP_AP5 which infects Yersinia enterocolitica of serotype O:3. Virol J 11, 188; doi: 10.1186/1743-422X-11-188 (2014).
Tugcu, D. et al. Successful treatment of multiresistant Achromobacter xylosoxidans bacteremia in a child with acute myeloid leukemia. Ann Saudi Med 35, 168–169 (2015).
Chen, Z. et al. IMP-1 encoded by a novel Tn402-like class 1 integron in clinical Achromobacter xylosoxidans, China. Sci Rep 4, 7212; doi: 10.1038/srep07212 (2014).
Wittmann, J. et al. First genome sequences of Achromobacter phages reveal new members of the N4 family. Virol J 11, 14; doi: 10.1186/1743-422X-11-14 (2014).
Wittmann, J., Dreiseikelmann, B., Rohde, C., Rohde, M. & Sikorski, J. Isolation and characterization of numerous novel phages targeting diverse strains of the ubiquitous and opportunistic pathogen Achromobacter xylosoxidans. PLoS One 9, e86935; doi: 10.1371/journal.pone.0086935 (2014).
Badalamenti, J. P. & Hunter, R. C. Complete Genome Sequence of Achromobacter xylosoxidans MN001, a Cystic Fibrosis Airway Isolate. Genome Announc 3, doi: 10.1128/genomeA.00947-15 (2015).
Lynch, K. H., Stothard, P. & Dennis, J. J. Comparative analysis of two phenotypically-similar but genomically-distinct Burkholderia cenocepacia-specific bacteriophages. BMC Genomics 13, 223; doi: 10.1186/1471-2164-13-223 (2012).
Veesler, D. & Cambillau, C. A common evolutionary origin for tailed-bacteriophage functional modules and bacterial machineries. Microbiol Mol Biol Rev: MMBR 75, 423–433, first page of table of contents (2011).
Zhang, J. & Inouye M., MazG, a nucleoside triphosphate pyrophosphohydrolase, interacts with Era, an essential GTPase in Escherichia coli. J Bacteriol 184, 5323–5329 (2002).
Hatfull, G. F. Bacteriophage genomics. Curr Opin Microbiol 11, 447–453 (2008).
Mobberley, J. M., Authement, R. N., Segall, A. M. & Paul, J. H. The temperate marine phage PhiHAP-1 of Halomonas aquamarina possesses a linear plasmid-like prophage genome. J Virol 82, 6618–6630 (2008).
Bazinet, C. & King, J. The DNA translocating vertex of dsDNA bacteriophage. Annu Rev Microbiol 39, 109–129 (1985).
Xu, J., Hendrix, R. W. & Duda, R. L. Conserved translational frameshift in dsDNA bacteriophage tail assembly genes. Mol Cell 16, 11–21 (2004).
Katsura, I. & Hendrix, R. W. Length determination in bacteriophage lambda tails. Cell 39, 691–698 (1984).
Bryan, M. J. et al. Evidence for the intense exchange of MazG in marine cyanophages by horizontal gene transfer. PLoS One 3, e2048; doi: 10.1371/journal.pone.0002048 (2008).
Haberer, K. & Maniloff, J. Adsorption of the tailed mycoplasma virus L3 to cell membranes. J Virol 41, 501–507 (1982).
Kiljunen, S. et al. Identification of the lipopolysaccharide core of Yersinia pestis and Yersinia pseudotuberculosis as the receptor for bacteriophage phiA1122. J Bacteriol 193, 4963–4972 (2011).
Zhao, X. et al. Outer membrane proteins ail and OmpF of Yersinia pestis are involved in the adsorption of T7-related bacteriophage Yep-phi. J Virol 87, 12260–12269 (2013).
Matsuda, T. et al. Lysis-deficient bacteriophage therapy decreases endotoxin and inflammatory mediator release and improves survival in a murine peritonitis model. Surgery 137, 639–646 (2005).
Kim, S. H. et al. Complete genome sequence of Salmonella bacteriophage SS3e. J Virol 86, 10253–10254 (2012).
Mishra, C. K., Choi, T. J. & Kang, S. C. Isolation and characterization of a bacteriophage F20 virulent to Enterobacter aerogenes. J Gen Virol 93, 2310–2314 (2012).
Sorensen, M. C. et al. Phase Variable Expression of Capsular Polysaccharide Modifications Allows Campylobacter jejuni to Avoid Bacteriophage Infection in Chickens. Front Cell Infect Microbiol 2, 11; doi: 10.3389/fcimb.2012.00011 (2012).
Filippov, A. A. et al. Bacteriophage-resistant mutants in Yersinia pestis: identification of phage receptors and attenuation for mice. PLoS One 6, e25486; doi: 10.1371/journal.pone.0025486 (2011).
Erridge, C., Bennett-Guerrero, E. & Poxton, I. R. Structure and function of lipopolysaccharides. Microbes Infect 4, 837–851 (2002).
Zhao, Y., Wang, K., Jiao, N. & Chen, F. Genome sequences of two novel phages infecting marine roseobacters. Environ Microbiol 11, 2055–2064 (2009).
Germida, J. J. & Casida, L. E. Ensifer adhaerens Predatory Activity Against Other Bacteria in Soil, as Monitored by Indirect Phage Analysis. Appl Environ Microbiol 45, 1380–1388 (1983).
Kutter, E. Phage host range and efficiency of plating. Methods Mol Biol 501, 141–149 (2009).
Pajunen, M., Kiljunen, S. & Skurnik, M. Bacteriophage phiYeO3-12, specific for Yersinia enterocolitica serotype O:3, is related to coliphages T3 and T7. J Bacteriol 182, 5114–5120 (2000).
Altschul, S. F. et al. Gapped BLAST and PSI-BLAST: a new generation of protein database search programs. Nucleic Acids Res 25, 3389–3402 (1997).
Darling, A. C., Mau, B., Blattner, F. R. & Perna, N. T. Mauve: multiple alignment of conserved genomic sequence with rearrangements. Genome Res 14, 1394–1403 (2004).
Bodnar, W. M., Blackburn, R. K., Krise, J. M. & Moseley, M. A. Exploiting the complementary nature of LC/MALDI/MS/MS and LC/ESI/MS/MS for increased proteome coverage. J Am Soc Mass Spectrom 14, 971–979 (2003).
Danis-Wlodarczyk, K. et al. Characterization of the Newly Isolated Lytic Bacteriophages KTN6 and KT28 and Their Efficacy against Pseudomonas aeruginosa Biofilm. PLoS One 10, e0127603; doi: 10.1371/journal.pone.0127603 (2015).
Acknowledgements
This work received support from National Natural Science Foundation of China Grant (31200137).
Author information
Authors and Affiliations
Contributions
E.L., J.Z. and Y.M. did the experiments and contributed equally to this study as joint first authors. X.W., H.L., W.L., X.W., C.L. and Z.S. analyzed the data. J.Z., R.Z., A.J., H.Y. and J.Y. provided the bacterial strains. X.Z. managed the project, designed the experiments and wrote the article.
Corresponding authors
Ethics declarations
Competing interests
The authors declare no competing financial interests.
Rights and permissions
This work is licensed under a Creative Commons Attribution 4.0 International License. The images or other third party material in this article are included in the article’s Creative Commons license, unless indicated otherwise in the credit line; if the material is not included under the Creative Commons license, users will need to obtain permission from the license holder to reproduce the material. To view a copy of this license, visit http://creativecommons.org/licenses/by/4.0/
About this article
Cite this article
Li, E., Zhao, J., Ma, Y. et al. Characterization of a novel Achromobacter xylosoxidans specific siphoviruse: phiAxp-1. Sci Rep 6, 21943 (2016). https://doi.org/10.1038/srep21943
Received:
Accepted:
Published:
DOI: https://doi.org/10.1038/srep21943
This article is cited by
-
Bacteriophage targeting microbiota alleviates non-alcoholic fatty liver disease induced by high alcohol-producing Klebsiella pneumoniae
Nature Communications (2023)
-
Characterization of sixteen Achromobacter xylosoxidans phages from Abidjan, Côte d’Ivoire, isolated on a single clinical strain
Archives of Virology (2020)
-
Characterization and genome comparisons of three Achromobacter phages of the family Siphoviridae
Archives of Virology (2017)
-
Comparative genomic analysis of Pseudomonas aeruginosa phage PaMx25 reveals a novel siphovirus group related to phages infecting hosts of different taxonomic classes
Archives of Virology (2017)
-
Isolation and characterization of a bacteriophage phiEap-2 infecting multidrug resistant Enterobacter aerogenes
Scientific Reports (2016)